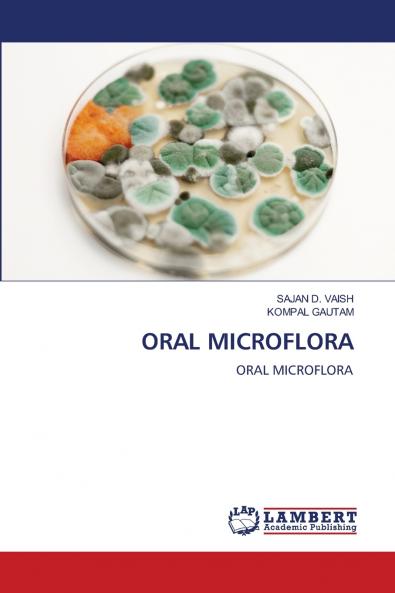
ORAL MICROFLORA

English
Paperback
₹5541
₹8879
37.59% OFF
(All inclusive*)
Delivery Options
Please enter pincode to check delivery time.
*COD & Shipping Charges may apply on certain items.
Review final details at checkout.
Looking to place a bulk order? SUBMIT DETAILS
About The Book
Description
Author
The Oral Cavity Is One Of The Most Complex Microbial Habotats. In The Human Body The Terminology Used To Describe Microorganisms In The Oral Cavity Refers To The Oral Microflora.In The Future It May Be Feasible To Target Treatment More Specifically To Particular Pathogens Or More Imaginative Approaches Could Be Used To Prevent Dis So In This Context The Outcome Of The Current Clinical Trial With Bacteriocin-producing Non-acidogenic But Lightly Competitive Strains Of S. Mutans Will Be A Great Relevance.
Delivery Options
Please enter pincode to check delivery time.
*COD & Shipping Charges may apply on certain items.
Review final details at checkout.
Details
ISBN 13
9786208119362
Publication Date
-27-09-2024
Pages
-124
Weight
-179 grams
Dimensions
-152x229x7.42 mm